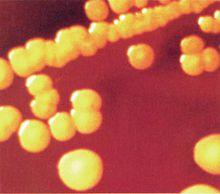
金黃色葡萄球菌

阿帕西林
基本信息
通用名稱:阿帕西林
英文名稱:Apalcillin
中文別名:阿帕西林鈉、蔡啶青黴素、奈啶青黴素、注射用阿帕西林鈉、萘啶青黴素
英文別名:Apalcillin Sodium、Elumota、Lumota、Palcin
用法用量:注射劑,成人一次2-3g,一日3次。
禁用慎用:青黴素過敏者忌用。
藥品簡介
 阿帕西林
阿帕西林阿帕西林(萘啶青黴素) ,特為一廣譜半合成的青黴素。特點為對多數綠膿桿菌有強大抗菌活性,較羧苄西林強30倍以上。對大多數腸桿菌屬細菌敏感。臨床主要用於綠膿桿菌及大腸桿菌等所致的感染。劑量為2g~3g/次,2次/日,肌注或靜注。不良反應有皮疹、發熱及血清丙氨酸氨基轉移酶升高等禁用於對青黴素過敏者,慎用於妊娠和哺乳期婦女,凡鹼性磷酸酯酶和轉氨酶增高者,應控制使用。
藥理藥效
阿帕西林抗菌譜較氨苄和羧苄青黴素廣。對革蘭陽性菌(包括厭氧球菌和桿菌)和對革蘭陰性菌均有較高活性。比較研究證明,對綠膿桿菌引起的小鼠感染,抗菌作用比羧苄青黴素強7~10倍;對大腸桿菌強2~15倍;對肺炎桿菌強8倍,對溶血性鏈球菌強2倍。
使用情況
藥理作用
 奇異變形桿菌
奇異變形桿菌阿帕西林為一廣譜的半合成青黴素。抗菌譜比氨苄青黴素和羧苄青黴素鈉寬,且作用強。它的作用譜包括革蘭陽性菌、沙門菌屬、志賀菌屬、梭狀芽孢桿菌屬、奈瑟菌屬、梭桿菌屬、大腸桿菌、肺炎桿菌、奇異變形桿菌和綠膿桿菌。對本品的耐藥菌有脆弱擬桿菌和耐氨苄青黴素的流感嗜血桿菌。對綠膿桿菌,本品的最低抑制濃度(MIC)為苄青黴素鈉的14.3%~33.3%。這是由於它有良好的親和力和細胞穿透力,並可抑制β-內醯胺酶。
在體內和羧苄青黴素比較的結果:對綠膿桿菌(T株)引起的小鼠感染,本品比羧苄青黴素強7~10倍,但不及慶大黴素有效;對綠膿桿菌No19及高毒力菌株(NC-5)則強4~7倍;對大腸桿菌(NIHJ)強2~15倍;對肺炎桿菌強8倍;對溶血性鏈球菌強2倍。體內活力一般低於體外。本品口服不吸收,與血清蛋白結合率高。在體內分布,以肝、腎、血清中的含量較高,腦中最低。排泄途徑,主要以原形通過膽汁排出。pH2時本品半衰期為4.7h。一般有效率為64%~72%。過敏反應比其他青黴素出現得多。
用法用量
注射給藥,成人和10歲以上兒童3次/d,每次2~3g;兒童按60~220mg/(kg·d)計算,分3~4次使用。
適應症
臨床可用於敏感革蘭陽性或陰性菌感染,如呼吸道、尿路、膽道、婦科感染,也可用於術後感染和五官科感染,均有較好療效。
不良反應
過敏反應比較多見. 用藥前應做過敏試驗.青黴素過敏者忌用. 有輕度或暫時性粒細胞減少.少數病人可出現暫時性血清轉氨酶升高.腎功能不全者可引起出血,紫癜. 劑量過大時水鈉瀦留.其它參見青黴素G.
不良反應面部潮紅、發熱、頭痛、過敏、腹瀉、噁心、血壓下降、鹼性磷酸酶和轉氨酶增高。
注意事項
套用人群
 氯化鈉注射液
氯化鈉注射液因可能發生過敏反應,所以對青黴素過敏者禁用。因對妊娠和哺乳期婦女使用尚無足夠經驗,故也應慎用。使用時肝酶濃度必須控制。Coombs試驗會出現假陽性結果。阿帕西林的半衰期為4.7小時。過敏反應較多見。用前應做青黴素應試。臨床套用中應考慮鈉輸入量。
臨床套用
治療急性細菌性感染
目的:評價注射用阿帕西林的有效性和安全性,並與特美汀比較。
方法:試驗組與對照組各61例。試驗組予注射用阿帕西林鈉4.5g,對照組予注射用特美汀3.2g,均分別加入100ml生理鹽水中靜滴,30min內滴完,q8h,療程均為7~14d。
結果:治療組有效率為93.4%,細菌清除率為96.4%,不良反應發生率為3.3%(2/61);對照組有效率為88.5%,細菌清除率為93.1%,不良反應發生率為4.9%(3/61)。統計學處理兩組差異無顯著性(P>0.05)。
結論:阿帕西林對下呼吸道、泌尿系細菌感染,尤其是產酶菌引起的感染,臨床療效好且不良反應少,是一種高效、安全的抗菌藥物。
前期驗證
病例選擇
採用隨機平行對照試驗設計。選擇年齡18~65歲的住院患者,經臨床確診為急性下呼吸道和泌尿道細菌性感染,共122例。試驗組與對照組各61例,其中呼吸道感染各31例,泌尿道感染各30例。兩組患者的性別、平均年齡、體重、感染的類型、體溫及WBC升高例數、病原菌分布情況、用藥量、用藥天數等指標相似,具有可比性。
用藥方法
試驗組:予注射用阿帕西林(海南三洋藥業有限公司,批號980704)4.5g,加入生理鹽水100ml中靜滴,30min內滴完,q8h,療程7~14d。
對照組:予注射用特美汀(美國史克美占製藥廠,批號54567B)3.2g,加入生理鹽水100ml中靜滴,30min內滴完,q8h,療程7~14d。
致病菌分離鑑定
在治療前2d內及治療結束後24h作細菌培養各1次。療程7d以上者,在治療過程中重複1次細菌培養。
體外抗菌活性測定:對所分離的細菌進行藥敏試驗(紙片法)。藥敏紙片包括哌啦西林、阿帕西林、阿米卡星、特美汀、頭孢他啶。對所分離的細菌用Netrocephin法進行β-內醯胺酶測定,計算產酶菌陽性率。
療效評定標準
根據衛生部1993年頒發的抗菌藥物臨床研究指導原則?進行評定。臨床療效按痊癒、顯效、進步、無效4級評定,痊癒與顯效合計為有效,並據此計算有效率;細菌學療效評價標準分細菌消除、未消除、替換3級,分別計算細菌陽性率、細菌消除率。
安全性評價
根據不良反應與試驗藥的關係進行評定,分為肯定有關、可能有關、可能無關、肯定無關和無法評價5級進行評定,以肯定有關+可能有關兩者合計來計算不良反應發生率。
統計學處理
t檢驗,χ2檢驗,Ridit檢驗。
 白細胞
白細胞白細胞試驗組治療呼吸道感染,症狀多在3~8d內明顯改善或消失,有發熱患者23例,平均(3.8±1.9)d退熱,有口羅音患者21例,平均(6.7±1.7)d口羅音消失;治療泌尿道感染,有發熱患者20例,平均(2.6±1.4)d退熱,有尿頻患者27例,平均(3.9±1.8)d消失,尿白細胞陽性30例,平均(3.4±1.7)d消失。對照組治療呼吸道感染,症狀多在4~8d內明顯改善或消失,有發熱患者22例,平均(3.9±2.0)d退熱,有羅音患者20例,平均(6.9±1.4)d口羅音消失,兩組比較差異均無顯著性;治療泌尿道感染,有發熱患者18例,平均(2.7±1.5)d退熱,有尿頻患者26例,平均(3.8±1.7)d消失,尿白細胞陽性30例,平均(3.2±1.9)d消失,兩組比較差異均無顯著性。
臨床療效
試驗組治療呼吸道感染和泌尿道感染臨床有效率分別為93.5%和93.3%,總有效率為93.4%;對照組有效率分別為90.3%,86.7%,總有效率為88.5%。兩組差異無顯著性。
細菌學療效
試驗組的61例中有55例分離出55株病原菌,細菌陽性率為90.2%(55/61),其中產酶株47株中產酶株47株,產酶陽性率為81.0%。
金黃色葡萄球菌
金黃色葡萄球菌金黃色葡萄球菌不良反應
試驗組和對照組分別有2例(1例皮疹,1例腹瀉)和3例(1例皮疹,2例腹痛和嘔吐)發生的不良反應與治療藥物可能有關,不良反應發生率分別3.3%和4.9%,經對症處理後均消失。
討論
本研究結果顯示,阿帕西林鈉治療急性細菌感染性疾病療效和不良反應均與文獻報導相似。細菌學試驗表明,阿帕西林鈉對臨床分離致病菌包括金葡菌、表葡菌、假單胞菌、不動桿菌等G+和G-菌均有強大殺菌作用,與國外文獻報導相似,其抗菌活性明顯強於哌啦西林和阿米卡星,差異有統計學意義,提示阿帕西林鈉可顯著提高哌拉西林的抗菌活性,對產酶菌和哌拉西林耐藥菌株顯示較強的協同抗菌效應。哌拉西林通過與青黴素結合蛋白(PBP)結合而抑制細菌細胞的合成,導致細胞壁的異常而破壞;但這種抗菌效果依賴於哌啦西林和靶蛋白的親和力及對β-內醯胺酶降解的穩定性。
他唑巴坦是許多β-內醯胺酶的強力抑制劑,擴展了哌啦西林原有的抗菌譜,包括許多產生β-內醯胺酶的細菌;與克拉維酸不同,後者可誘導一些AmpC型一類酶,他唑巴坦對這類酶誘導作用非常微弱,對哌拉西林的活性沒有或僅有極小的拮抗作用。上述臨床研究表明,作為β-內醯胺類抗生素和β-內醯胺酶酶抑制劑的複合製劑的新品種,注射用阿帕西林鈉對臨床常見的致病菌引起的急性下呼吸道感染、泌尿系統感染,尤其是產酶菌引起的嚴重的感染,臨床療效好且不良反應發生率較低,有較高的臨床套用價值。
案例分析
引發青黴素腦病
 神經系統
神經系統患者,女,67歲。因反覆咳嗽、咳痰5年,加重伴喘促5天入院,患者32年前體檢發現患有多囊腎,無青黴素過敏及癲癇病史。入院查體:R26次/min,P108次/min,BP145/93mmHg,口唇無發紺,雙肺可聞及大量濕性囉音和少許乾性囉音,心臟聽診心律齊,各瓣膜聽診區未聞及病理性雜音,肝脾肋下未觸及,右側腹平臍可觸及腫大腎臟,左側無觸及,雙側腎區有少許叩擊痛,顏面四肢無水腫,神經系統查體無異常。查血常規:WBC15.2×109/L,RBC3.1×1012/L,HGB106g/L,W-SCC1.1×109/L,W-LCC9.4×109/L;腎功能:BUN10.2mmol/l,CRE286μmol/l,肝功能正常,ESR48mm/h;血生化:血鉀4.8mmol/L,ICA1.2mmol/L;尿常規:PRO(+),BLD(+),未見管形。B超:雙腎增大,以右側為甚,雙腎多發性囊腫。X線胸片:桶狀胸,符合慢性支氣管炎改變,雙下肺感染。
給予阿帕西林(每瓶含哌拉西林2.0g,他唑巴坦0.25g)2瓶+生理鹽水100mlq8h靜脈滴注,配合化痰治療。用完第8次後患者出現面肌及四肢陣發性肌肉痙攣及抽搐,並伴意識障礙,查體:肺部囉音較入院時明顯減少,口唇無發紺,R24次/min,床邊心電監護血氧飽和度99%,BP150/95mmHg,HR98次/min,血氣分析無明顯缺氧及二氧化碳瀦留表現。患者四肢肌力未能很好地配合檢查,四肢肌張力正常對稱,四肢未引出病理征,余神經系統檢查無異常,未排除有腦血管意外的可能,給予行頭顱螺鏇CT檢查,但未發現異常腦實質病變。考慮青黴素腦病而停用該藥,並給予安定針對症治療。經治療後患者肌肉陣攣及抽搐消失,第二天患者意識恢復正常,無任何後遺症。患者經改用頭孢派酮舒巴坦鈉治療後肺部囉音消失。
討論
 呼吸道
呼吸道青黴素因其毒性低而被臨床普遍套用。但一次用量過大或持續大劑量套用時,也會對患者產生神經系統損害,稱為青黴素腦病。臨床上以靜滴青黴素G鈉(或鉀)鹽與氨苄西林引起青黴素腦病多見,且多發生於新生兒、兒童和老年人。本例患者靜滴阿帕西林鈉引起青黴素腦病臨床上非常少見,該藥為哌拉西林鈉和他唑巴坦鈉組成的複方製劑,其中哌拉西林為廣譜半合成青黴素類抗生素,他唑巴坦為β-內醯胺酶抑制劑。該藥兩種成分主要由腎排出,腎功能受損患者的哌拉西林和他唑巴坦半衰期隨著肌酐清除率的下降而延長。該藥對哌拉西林敏感的革蘭陰性、陽性菌,厭氧菌和產β-內醯胺酶耐哌拉西林的細菌均有明顯的抗菌作用,因而被廣泛套用於呼吸道、腹腔、盆腔及泌尿系感染患者。
它的不良反應有:皮膚反應如皮疹、瘙癢等;消化道反應如腹瀉、噁心、嘔吐等;過敏反應;局部反應如疼痛、靜脈炎、水腫等。人們普遍注重青黴素類的過敏反應,而對少發的青黴素腦病缺乏認識,常引起誤診及漏診。本例患者出現典型的青黴素腦病的症狀及體徵,表現為面肌和四肢肌肉的陣發性痙攣及抽搐,並伴有意識障礙,且能排除肺性腦病及腦血管意外的可能,故青黴素腦病診斷無誤,考慮為哌拉西林用量較大,且患者年老、血漿白蛋白減少及腎功能不全,導致腎排出受限引起血藥濃度升高和腦脊液藥物濃度升高,從而產生中樞神經系統毒性反應。哌拉西林引發青黴素腦病較為少見,且易與其他原因引起的腦病相混淆,故在臨床工作中應警惕本病的發生,以便及時停藥及治療。
阿帕西林鈉合成簡介
【CA登記號】[58795-03-2]
【結 構 式】
【分 子 式】C25H22N5NaO6S·H2O
【分 子 量】561.56
【收錄藥典】
【開發單位】Thomae(德國)
【首次上市】1982年,德國
【性 狀】白色粉末。極易溶於水,易溶於乙醇,不溶於乙醚和三氯甲烷。mp265℃(dec)
【用 途】
廣譜抗生素。對革蘭陽性菌、沙門菌屬、志賀菌屬、梭狀芽孢桿菌屬、奈瑟菌屬、梭狀菌屬、大腸
桿菌、肺炎桿菌、奇異變形桿菌和綠膿桿菌均有良好抑制作用。用於對本品敏感菌所引起的感染,包括
呼吸道感染、泌尿生殖道感染、膽道感染、婦科、腹部和手術後感染。
【推薦合成路線】
一、3-乙氧羰基-4-羥基-1,5-萘啶(2)的製備
在乾燥反應瓶中,加入3-氨基吡啶23.5g(0.25mol)、乙氧甲叉丙二酸二乙酯54g(0.25mol),攪拌加
熱至150℃,蒸出乙醇,回流1h,冷卻,析出固體,過濾,濾液用石油醚洗至洗滌液無色為止,乾燥,得
(2)45g(82%)
二、3-羧基-4-羥基-1,5-萘啶(3)的製備
在反應瓶中,加入(2)68g(0.31mol)、4%氫氧化鈉700ml,加熱攪拌回流6h後,加入活性炭脫色數分
鍾,過濾,濾液用10%鹽酸調至pH3,析出固體,冷卻,過濾,水洗,乾燥,得(3)44g(78%)。
三、4-羥基-1,5-萘啶-3-甲醯氯鹽酸鹽(4)的製備
在乾燥反應瓶中,加入N,N-二甲基甲醯胺0.73g(0.01mol)、氯化亞碸1.56g(0.01mol)和無水苯50ml
,於攪拌下加入(3)1.9g(0.01mol),於40~85℃攪拌3h,冷卻,析出結晶,用苯洗滌,真空乾燥,得(4)
2.37g(96%),mp<350℃。
四、4-羥基-1,5-萘啶-3-甲酸N-丁二醯亞胺酯(5)的製備
在乾燥反應瓶中,加入N-羥基丁二醯亞胺(NHS)22.2g(0.2mol)、三乙胺35.5g和N,N-二甲基甲醯胺
800ml,分數次加入(4)43.2g(0.18mol),逐漸加熱至60℃,攪拌0.5h,加入三乙胺1.77g,繼續保溫攪拌
1h。反應畢,冷卻至30℃,析出結晶,過濾,依次用二氯甲烷、丙酮洗滌,乾燥,得(5)34.2(66%),
mp310~311℃(dec)。 五、阿帕西林三乙胺鹽(6)的製備
在反應瓶中,加入二甲基亞碸12ml,三乙胺2g(0.02mol)、氨卞青黴素三水合物4.16g(0.01mol)和
(5)2.87g(0.01mol),於室溫攪拌溶解後,加入丙酮適量,析出結晶,過濾,濾餅用丙酮洗滌,乾燥,得
(6)5.33g(85%),mp210℃。
六、阿帕西林鈉(1)的合成
在反應瓶中,加入(6)8.5g(0.02mol)、2-乙基己酸鈉2.6g(0.02mol)和二甲基亞碸30ml,攪拌溶解後
,加入丙酮300ml,析出固體,過濾,乾燥,得粗品(1)。用甲醇-丙酮重結晶,得白色粉末精品(1)6.7g
(60%),mp265℃(dec)。
【光譜數據】
IR(KBr): 1770,1650cm
H-NMR(CD3SOCD3):δ11.32(s,1H),9.2(d,1H),8.98(brs,1H),8.78(d,1H),8.33(d,1H),
7.2~7.9(m,6H),6.1(d,1H),5.25~5.67(m,2H),4.07(s,1H),1.60(s,3H),1.47(s,3H)。

